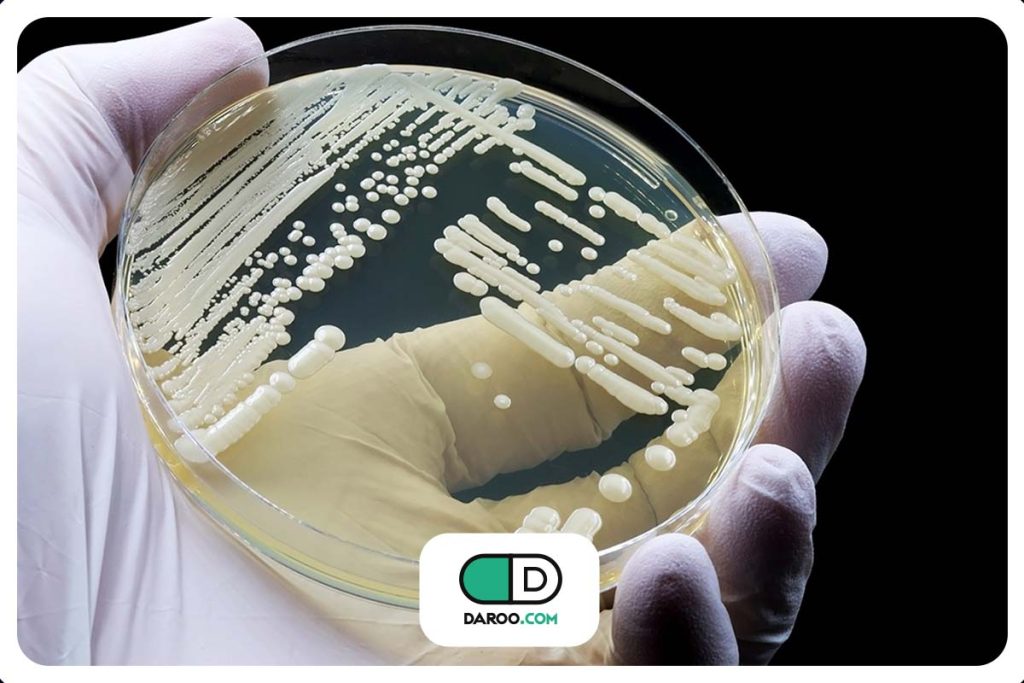
کاندیدا اوریس چیست

کاندیدا اوریس چیست و چه خطراتی دارد؟


کارشناسان بهداشت جهانی نسبت به تهدید فزاینده یک قارچ کشنده که در حال حاضر در ۶۱ کشور در حال گسترش است، هشدار میدهند. این قارچ مقاومت فزایندهای در برابر داروها و ظرفیت بالای ایجاد بیماری نشان میدهد، به طوری که میزان مرگ و میر در بین افراد آلوده بیش از ۵۰٪ تخمین زده میشود. با ما در این مطلب از دارو دات کام همراه باشید تا با این قارچ کشنده بیشتر آشنا شویم.
کاندیدا اوریس چیست؟
شیوع کاندیدا اوریس، که به عنوان قارچ عامل بیماری لکه سفید نیز شناخته میشود، بخشی از یک روند گستردهتر است. عفونتهای قارچی به طور کلی سالانه تقریباً ۶.۵ میلیون نفر را تحت تأثیر قرار میدهند و بیش از نیمی از افراد آلوده، حتی با درمانهای موجود، جان خود را از دست میدهند.
کاندیدا اوریس، نوعی مخمر مهاجم، به ویژه به دلیل تواناییاش در ایجاد عفونتهای کشنده، به ویژه در افراد دارای سیستم ایمنی ضعیف، شناخته شده است. پس از کشف اولیه آن در کانال گوش یک بیمار در ژاپن در سال ۲۰۰۹، این قارچ به سرعت در دهها کشور از جمله هند گسترش یافت، که در سال ۲۰۱۴ آن را یک تهدید عمده برای سلامت عمومی اعلام کرد.
آخرین بررسیهای علمی مجموعهای از ویژگیهای منحصربهفرد را نشان میدهد که به این قارچ امکان گسترش سریع میدهد. اکنون این قارچ در حداقل ۶۱ کشور در شش قاره شناسایی شده است. از جمله این ویژگیها، توانایی قارچ در تبدیل سریع از شکل مخمر مانند معمول خود به رشد رشتهای است که گسترش آن را تسهیل میکند.
علاوه بر این، این قارچ دارای پروتئینهای خاصی در دیواره سلولی خود است که آن را قادر میسازد مانند چسب به پوست انسان بچسبد و آن را استعمار کند. این استعمار پوستی، همانطور که در مطالعه منتشر شده در مجله Microbiology and Molecular Biology Reviews نشان داده شده است، یک نگرانی جدی پزشکی است، زیرا میتواند بیماران حامل قارچ را به حاملان در بیمارستانها تبدیل کند و در نتیجه دایره عفونت را گسترش دهد.
خطر این قارچ محدود به گسترش سریع آن نیست؛ بلکه از طریق مکانیسمهای پیچیده به ایجاد مقاومت دارویی نیز گسترش پیدا میکند. این قارچ مجهز به چیزی است که اساساً پمپهای دفع روی غشای سلولی خود هستند که داروهای ضد قارچ را قبل از اینکه بتوانند روی آن تأثیر بگذارند، دفع میکنند. همچنین میتواند برای تشکیل لایههای چسبنده (بیوفیلم) روی سطوح مختلف، از آن محافظت کرده و مانع نفوذ دارو شود. سوالاتی در مورد اینکه آیا مکانیسمهای دیگری برای مقاومت در برابر درمانها دارد یا خیر، باقی مانده است.
وضعیت با مشکلات تشخیصی مرتبط با این قارچ، پیچیدهتر میشود. شناسایی اشتباه یا اشتباه گرفتن با سایر قارچها، شروع درمان مناسب را به تأخیر میاندازد و منجر به بدتر شدن عفونتها و افزایش احتمال مرگ میشود.
با توجه به این یافتههای نگرانکننده، این بررسی علمی بر نیاز فوری به توسعه داروهای ضد قارچی جدید با طیف وسیعی از فعالیت و بهبود روشهای تشخیصی برای نتایج سریعتر و دقیقتر تأکید میکند. همچنین خواستار توسعه درمانهای حمایتی مبتنی بر تقویت سیستم ایمنی یا واکسنها، به ویژه برای بیماران پرخطر است.
این بررسی همچنین بر تلاشهای بیشتر برای افزایش آگاهی در مورد این بیماری قارچی و تقویت مکانیسمهای نظارت و پایش جهانی، به ویژه در کشورهای با منابع محدود، تأکید میکند. در عین حال، به کورسوی امیدی اشاره میکند: سه داروی جدید که در حال حاضر تحت آزمایشهای بالینی هستند، ممکن است به زودی به سلاحهای اضافی در مبارزه با این تهدید رو به افزایش سلامت جهانی تبدیل شوند.
مطالب این مقاله صرفاً جهت اطلاعرسانی است و هرگز جایگزین توصیه، تشخیص یا درمان پزشک متخصص نمیشود. قبل از هرگونه تصمیم درمانی، ابتدا با پزشک خود مشورت کنید.
منابع مقاله:
ایندیپندنت

نظرات